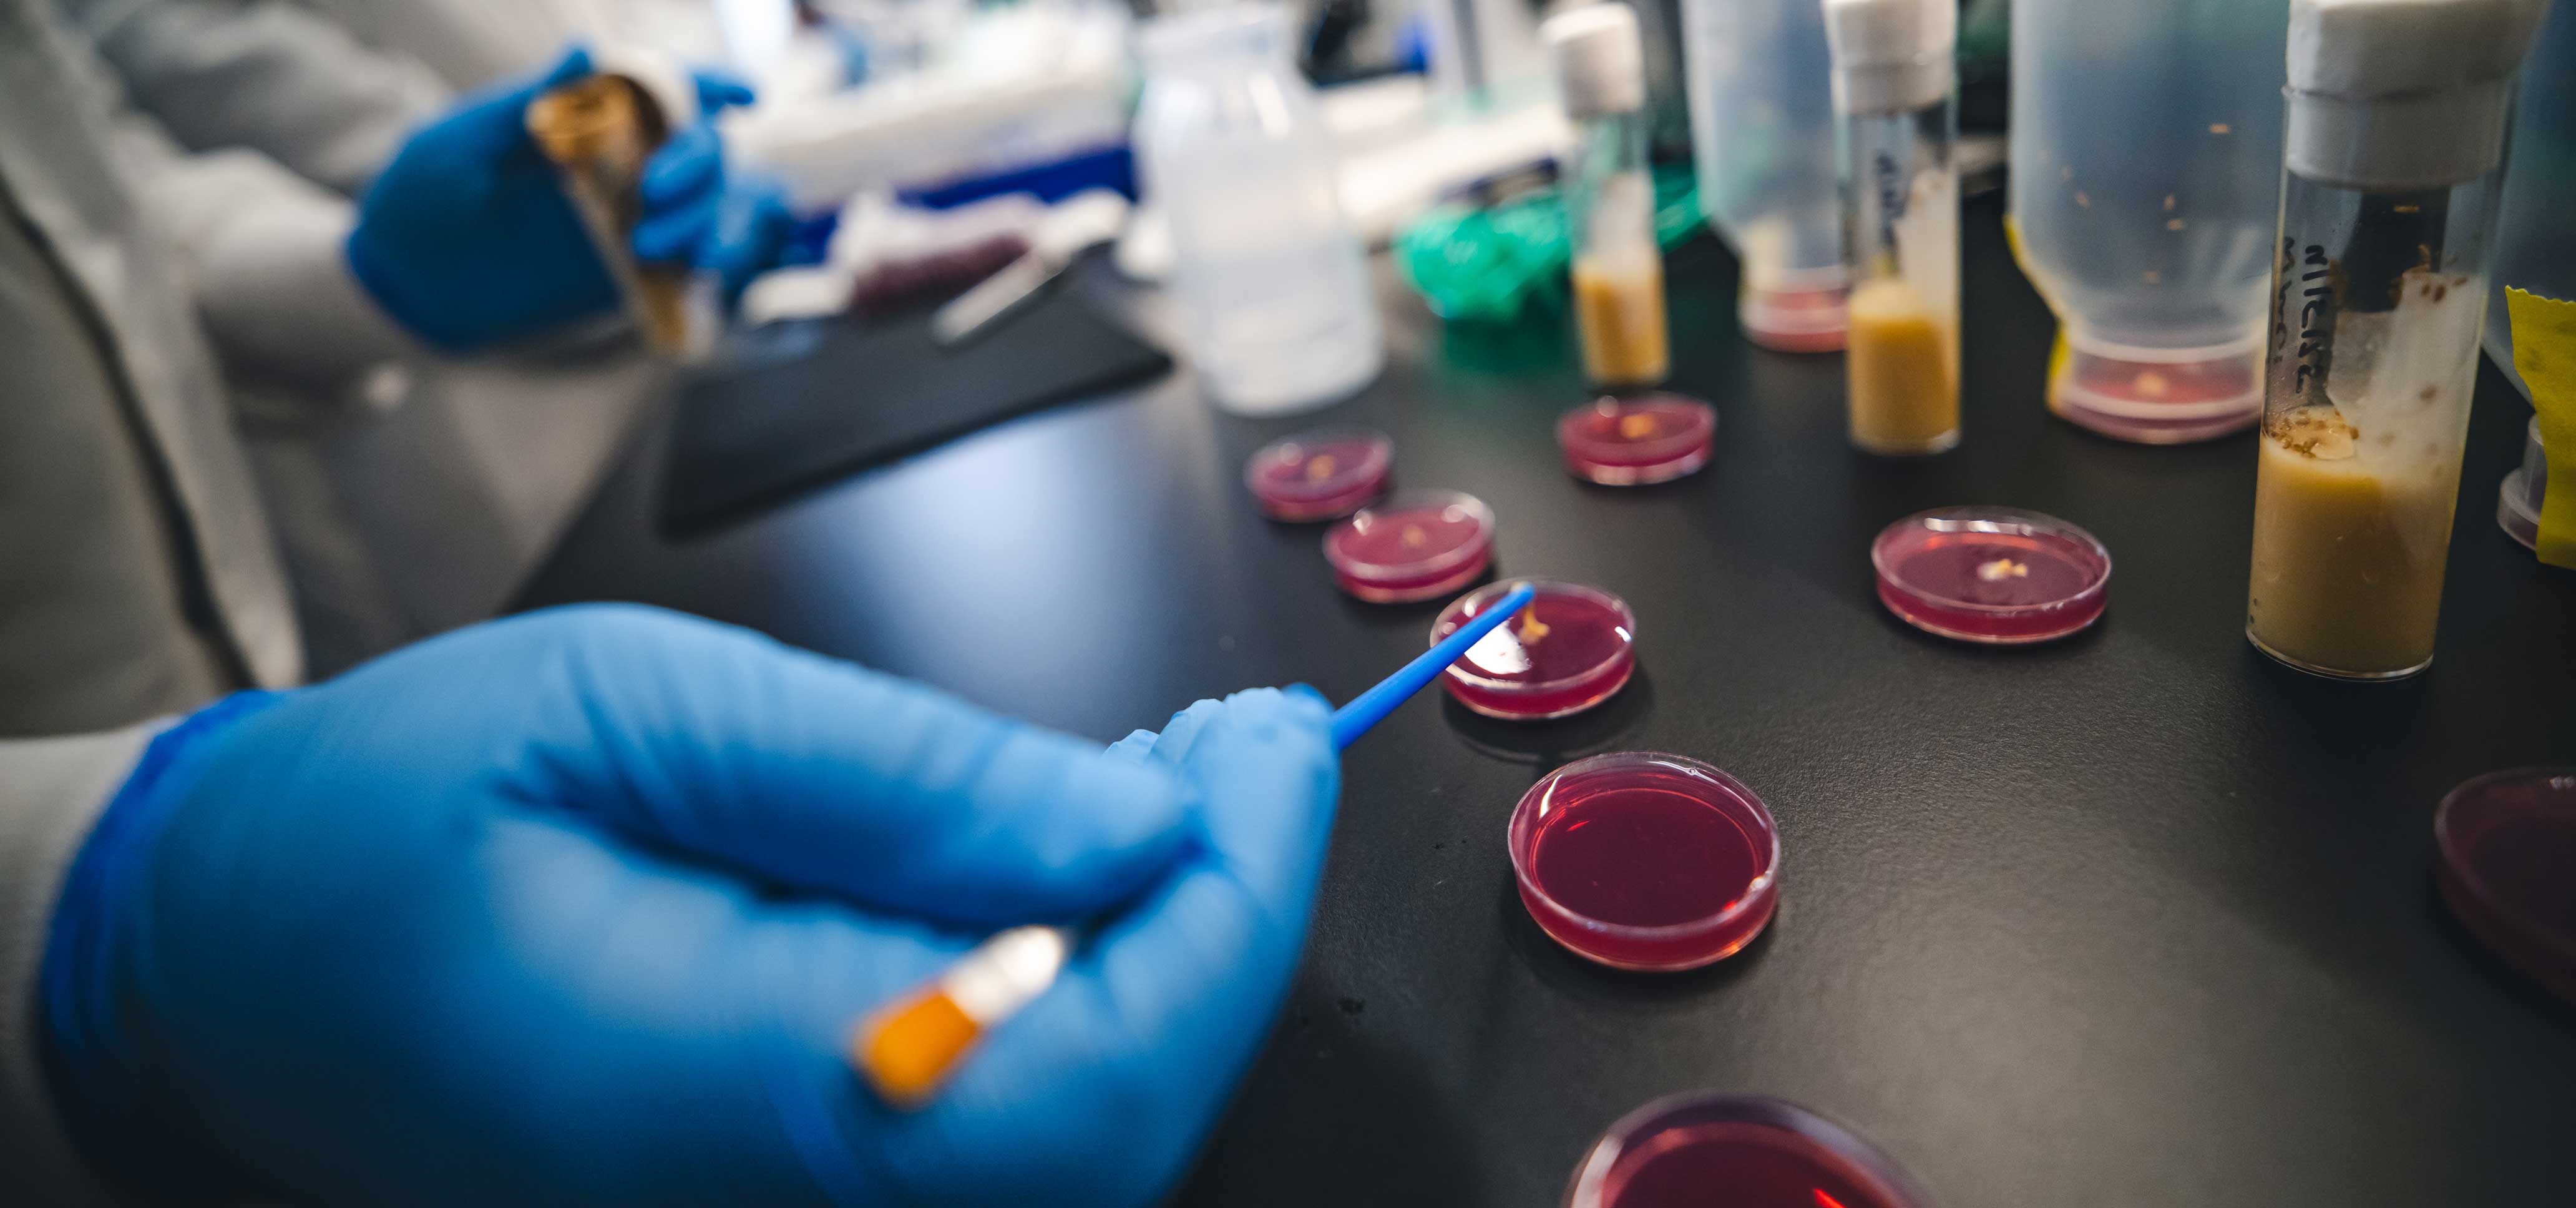
A gloved hand holding a pipette in a lab.

The most transformative breakthroughs and significant economic impacts occur at the intersection of academic discovery and real-world application of knowledge. As a leading R1 research institution, Lehigh moves beyond transactional arrangements to focus on deep, sustained collaboration that aligns with our core mission of education, discovery, and service. We seek partners who share a vision for long-term impact and are interested in engaging across multiple facets of the university.
Ways to Work Together
When you partner with Lehigh, you gain access to faculty expertise and research solutions in a variety of emerging areas, including in science, engineering, technology, business, and more. Opportunities include:
- Sponsored research opportunities
- Collaborative research applications to external funding entities
- State-of-the-art facilities and instruments
- Participation in advisory boards
- Research consortia
- Research support through philanthropy
- Flexible engagement AI models to accelerate innovation, including AI in Business Research Lab (AI-BRL) and the Institute for Data, Intelligent Systems, and Computation (I-DISC)

Partnering with Lehigh enables you to build your employee pipeline through connections with graduate and undergraduate students who meet your recruitment needs.
Opportunities include:
- Sponsored capstone projects or internships
- Support for Ph.D. or postgraduate students
- Recruitment through Lehigh’s Center for Career and Professional Development
- Connection with AI-ready students

Take advantage of quality degree programs and certificate offerings to educate your employees, including:
- MBA and executive education
- Customized training, professional development, and certificate programs
- Graduate and professional studies
- Programs and certificates to build AI literacy and upskill your team
Lehigh University is proud to partner with EdAssist and EdCor to support working professionals in advancing their careers through graduate education. Through this partnership, eligible employees of EdAssist-affiliated companies or EdCor affiliated companies can receive a 20% tuition discount on select Lehigh graduate programs. Questions on Lehigh graduate programs can be addressed by each college:
- College of Arts & Sciences: incasgrd@lehigh.edu
- College of Business: incbgrad@lehigh.edu
- College of Education: coe-admissions@lehigh.edu
- College of Health: cohgrad@lehigh.edu
- P.C. Rossin College of Engineering and Applied Science: engineering@lehigh.edu

Advance your research, upskill your team, and access talent with Lehigh as your strategic partner in AI innovation. Lehigh provides a multi-disciplinary approach to AI applications, ensuring that technology is developed and applied with business, engineering, and ethical excellence in mind. With Lehigh, you can:
- Explore AI consultation services leveraging the talent of AI-ready students and faculty
- Advance research with access to world-class faculty and state-of-the-art facilities
- Partner with the AI in Business Research Lab (AI-BRL), dedicated to the intersection of AI and commerce
- Engage with the Institute for Data, Intelligent Systems, and Computation (I-DISC), a hub that catalyzes advancements in machine learning and data mining, autonomous systems and robotics, large language models (LLMs) and more
- Connect with AI-ready graduates through capstone projects, internships and recruitment, and specialized programs
- Build in-house AI literacy through executive education, graduate certificates, and an executive certificate in AI and analytics

Lehigh’s campuses offer historic campus charm, inspiring industrial spaces for large-scale experimentation, and acres of natural beauty. Co-location prompts serendipitous interactions, reduces communications barriers, and allows you to move from transactional to strategic collaboration. When you co-locate, you are able to:
- Directly engage with faculty, departments, and centers
- Gain access to state-of-the-art labs, offices, conference space, and instrumentation
- Plug into a talent pipeline of undergraduate, graduate, and PhD students
- Enjoy the benefits of academic symposia, lectures, and other campus events
- Serve on advisory boards and have a voice in new research directions and projects

Gain visibility for your business or organization in the community through sponsorships for Lehigh Athletics, Zoellner Arts Center, Lehigh University Art Galleries, and other programs, or support Lehigh’s students and programs philanthropically.
Lehigh is a resource and a partner for the community, offering a range of services and points of connection.
- Innovate and scale through our Small Business Development Center, Manufacturers Resource Center, or Ben Franklin Technology Partners.
- Work with Conference Services to arrange for your banquet, seminar, meeting, or summer camp.
- Real Estate Services is responsible for managing all aspects of the University's real estate operations including the acquisition, leasing, development, and disposition of University real estate as well as property management.
Discover More
Featured Opportunities
Center for Career and Professional Development
Build your talent pipeline and achieve your recruitment goals.
Office of Technology Transfer
Bring your innovations to the world by connecting with Lehigh's cutting-edge technologies and researchers.
Meet Our Research Teams
Convene with Lehigh teams around shared research goals and interests.
Connect with CFR
Build a Partnership
306 S. New Street, Suite 500
Bethlehem, PA 18015-1652
(610) 758-6408
aeb723@lehigh.edu